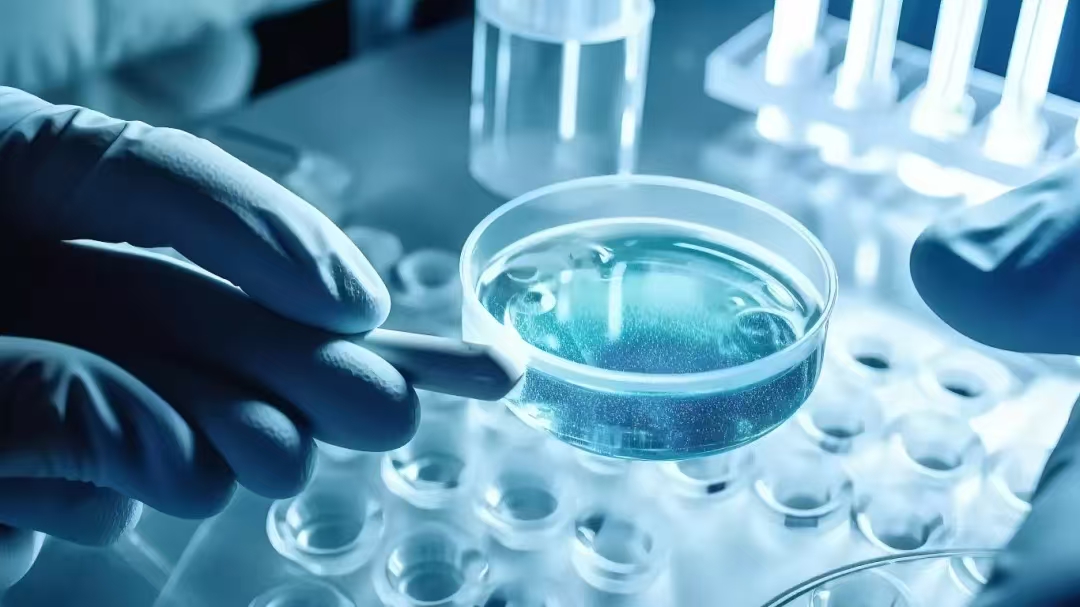
1735352030139444.jpg 微信图片_20241228101128.jpg

【最新】长三角一体化示范引领作用显著,区域发展指数进一步提升
上海发布 品牌长三角
市统计局介绍,根据《长三角一体化发展统计监测工作方案》和监测制度,长三角一体化发展统计监测办公室(上海市统计局)测算结果显示,2023年长三角区域发展指数为132.6(以2015年为基期),比2022年提高3.3。自2018年长三角一体化发展上升为国家战略以来,长三角区域发展指数年均提高3.3,六个分项指数均有所上升。其中,创新共建、协调共进和绿色共保分项指数提升较快,与2018年相比,年均提高超5.0;示范引领和民生共享分项指数稳步提高,年均分别提高2.2和3.3;开放共赢分项指数逐步恢复、波动上升,年均提高0.2。详见↓
长三角一体化示范引领作用显著
区域发展指数进一步提升
长三角一体化发展统计监测办公室
2024年12月23日

图:2015—2023年长三角区域发展指数
(以2015年为基期,基期指数为100)

一、经济总量迈上新台阶,示范引领作用彰显

长三角区域示范引领指数稳步增长,2023年为126.9,比2022年提高2.9,与2018年相比年均提高2.2。
2023年,长三角一体化示范引领作用显著,区域经济总量迈上新台阶,突破30万亿,实现地区生产总值30.50万亿元,是2018年的1.4倍(按现价计算),占全国比重为24.4%。区域一般公共预算收入从2018年的2.54万亿元稳步增加到2023年的3.08万亿元,占全国地方一般公共预算收入比重为26.3%。根据有关部门发布的《国家信息化发展报告(2023年)》,在2023年全国31个省(自治区、直辖市)信息化综合发展水平评价中,长三角区域位居前列。
二、研发投入超万亿,创新共建效果显著

长三角区域创新共建指数提高显著,2023年为154.3,比2022年提高5.0,与2018年相比年均提高6.0。
2023年,长三角区域研发投入快速增长,区域研究与试验发展(R&D)经费投入迈上万亿台阶,达10167亿元,是2018年的1.7倍,投入总量占全国30.5%;区域研发投入强度达3.33%,高于全国平均水平0.68个百分点,提前实现《长江三角洲区域一体化发展规划纲要》2025年研发投入强度达到3%以上的发展目标;三省一市研发投入强度均超过全国平均水平。2023年,长三角区域新增发明专利超过24万件,每万人新增发明专利拥有量超过10件,与2018年相比,均增长1.2倍。科技创新共同体建设取得成效,由国家实验室、国家重点实验室、重大科技基础设施等共同构成的长三角战略科技力量稳步壮大,2023年区域规模以上工业战略性新兴产业总产值占规模以上工业总产值比重逐年提高。
三、互联互通再加速,协调共进稳步提高
长三角区域协调共进指数逐年提高,2023年为130.2,比2022年提高1.6,与2018年相比年均提高5.1。
区域基础设施互联互通水平持续提高。2023年末,长三角区域铁路运营里程达1.46万公里,铁路路网密度达到406公里/万平方公里,比2018年末增长36.7%;高速公路里程达1.73万公里,高速公路密度达到482公里/万平方公里,比2018年末增长17.0%;区域内铁路路网密度、高速公路密度的省际差异相比2018年末明显缩小。长三角区域协调发展稳步推进,2023年区域人均国内生产总值达12.86万元,省际差距由2018年的2.60:1缩小至2.48:1;居民人均可支配收入省际差距由2018年的2.68:1缩小至2.43:1,四地城乡居民收入比继续缩小,上海城乡居民收入比由2018年的2.24:1缩小至2023年2.08:1,江苏由2.26:1缩小至2.07:1,浙江由2.04:1缩小至1.86:1,安徽由2.46:1缩小至2.24:1。
四、生态环境持续改善,绿色共保成效显现

长三角区域绿色共保指数在各分项指数中提升最快,2023年达到159.7,比2022年提高7.7,与2018年相比年均提高5.9。
2023年,长三角区域生态环境共保联治进一步加强,生态环境质量明显改善,区域环境空气PM2.5平均浓度为32微克/立方米,比2018年下降27.3%;长三角41个城市空气质量指数(AQI)平均优良天数比例平均为83.7%,比2018年上升9.6个百分点。2023年,594个地表水国控断面水质优良比例为93.4%,达到历史最好水平。区域绿色低碳转型取得进展,区域废气二氧化硫排放量比2018年下降约七成。
五、外贸规模创新高,开放共赢平稳推进

长三角区域开放共赢指数提高,2023年为108.2,比2022年提高0.2
2023年,长三角区域高水平开放持续扩大,区域货物进出口总额15.17万亿元,创历史新高,是2018年的1.4倍,占全国货物进出口总额比重为36.3%。2023年,实际利用外资717亿美元,占全国比重为43.9%,比上年提升3.8个百分点。2023年,区域内地区间铁路货运流量3990万吨,是2018年的1.8倍。2023年第六届进博会超过3400家参展商参展,440多项首发新产品、新技术、新服务集中展示,意向成交金额784.1亿美元,比2018年首届进博会增长35.6%。
六、公共保障有力有效,民生福祉持续增进

长三角区域民生共享指数稳步增长,2023年为129.2,比2022年提高3.2,与2018年相比年均上升3.3。
2023年,长三角区域民生福祉持续增进,区域人均公共财政支出达1.93万元,是2018年的1.3倍,比全国平均水平高15%左右。每千人拥有三甲医疗机构床位数约1.7个,是2018年的1.3倍。长三角区域社会保障卡居民服务一卡通取得阶段性成效,区域内居民凭社会保障卡即可办理公安、民政、人社、医保等领域的政务事项,截至2023年底已推动173项政务服务事项跨省通办,以社会保障卡为载体实现52个居民服务事项“一卡通”。
资料:市统计局、长三角一体化发展统计监测办公室
编辑:方雅欣








